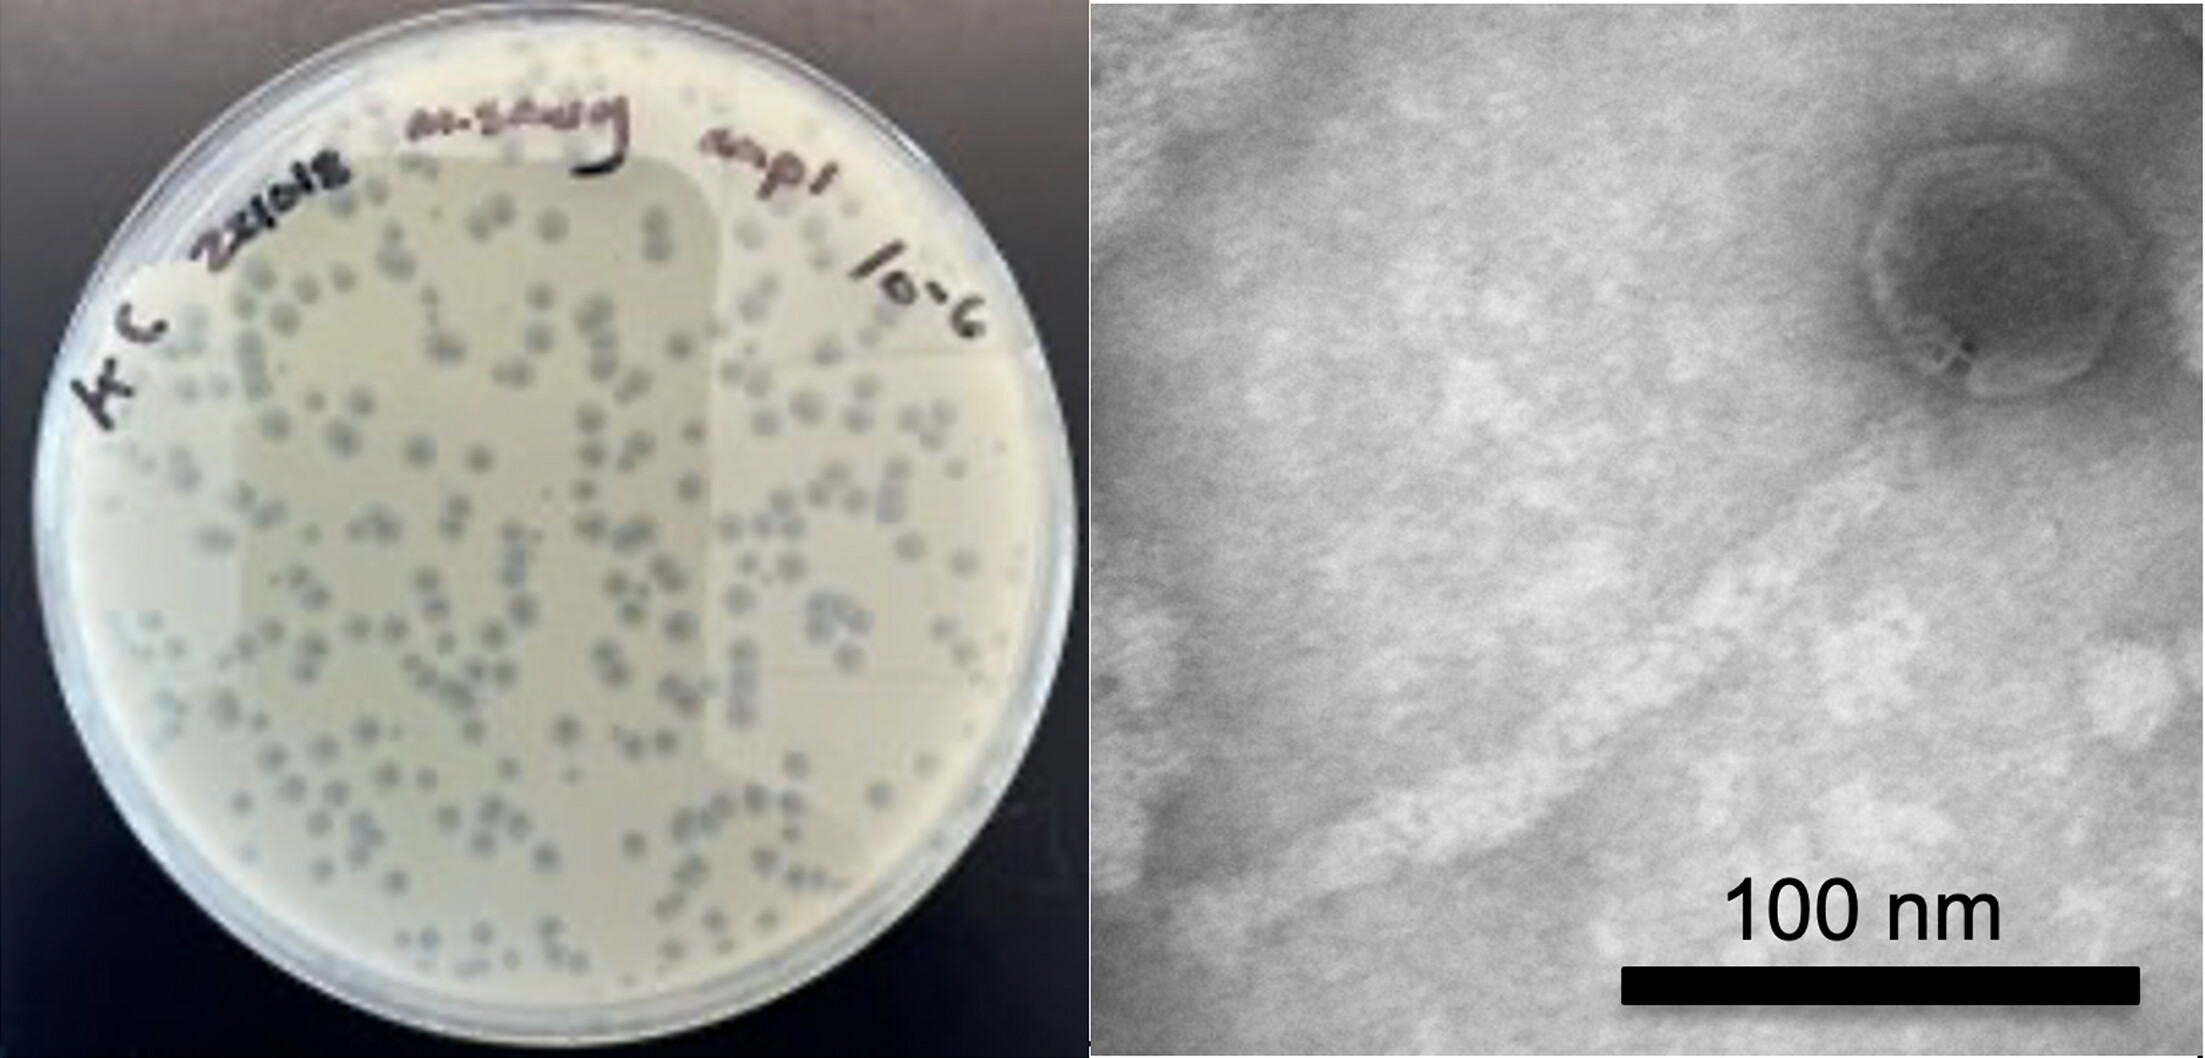
cover image

Kate Carline — HTGAA Spring 2026

About me
Kate Carline is a fourth year undergraduate student studying Biology and Public Policy with a focus on synthetic biology and bacteriophage. She has published her research three times, including as first author for her work on William & Mary’s iGEM team, a globally-recognized group researching engineered bacteria and phage in soil, and in Dr. Margaret Saha’s SEA-PHAGES Lab, where she characterized a novel phage named Discoknowium. In addition to her work as a committed listner and a TA for the new HTGAA W&M node, Kate is currently participating in Honors research where she is investigating microbial community editing.
Contact info
Homework
- Week 1: Principles and Practices
- Week 10 - Advanced Measurement & Measurement Technology
- Week 11 - Bioproduction & Cloud Labs
- Week 2: DNA Read, Write, Edit
- Week 3: Automation
- Week 4: Protein Design 1
- Week 5: Protein Design II
- Week 6: Genetic Circuits I
- Week 7: Genetic Circuits II
- Week 8 - Cell Free Systems